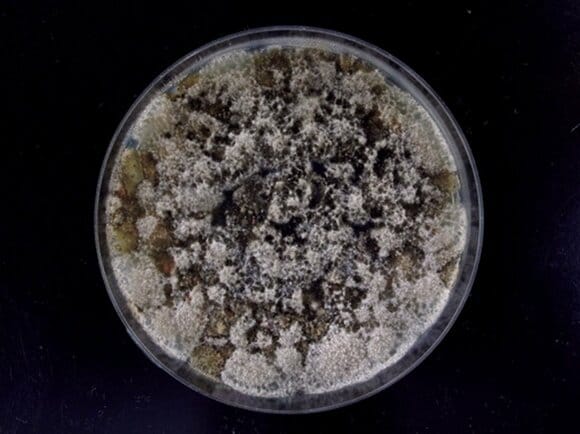

カビ・ダニ被害を防ぐには、敵の居場所を知ることから。カビ・ダニ博士の川上裕司がESSEレポーターHさんのお宅を訪問し、危険地帯を解明。さらに掃除のプロ・高橋敬子さんに退治&予防法を教わりました。これらを覚えておけば対策もバッチリです。
ジメジメした季節に繁殖しやすいカビ・ダニ。夏前にしっかり対策をして、増殖を防いで
気温と湿度が上昇する梅雨どきは、カビ・ダニが活発になる季節。
「カビ・ダニは、温度20~30℃、湿度70%以上の環境が大好き。ホコリ、食品や石けんのカスなど室内の汚れを栄養源にし、繁殖します。これからの時季は汚れ落としを徹底し、湿気をためない工夫が欠かせなくなります」と話すのは、カビ・ダニ博士の川上裕司さん。
カビ・ダニが危険といわれる理由は、住環境への悪影響はもちろんのこと、健康被害を引き起こす原因になるから。「カビの胞子を吸い込むと、アレルギーを発症させる発端になります。カビが増殖する環境では、細菌も繁殖するので、食中毒の危険性もあります。また、ダニは吸い込むと、ぜんそくや鼻炎、アトピー性皮膚炎を引き起こすことも。ダニの死骸やフンでもアレルゲンになるんですよ」。
今回、川上さんが子どものアレルギーに不安がある読者宅を訪問。カビ・ダニが繁殖しやすく、見落としがちな場所を徹底チェックし、危険度を分析してもらいました。
カビ・ダニの生態と危険地帯を理解したら、対策を。教えてくれたのは、掃除のプロ・高橋敬子さん。
「カビ・ダニ対策は、ポイントを押さえた退治&予防法を知ることが大切。カビも早めに落とせば、労力はわずか。洗剤も最低限ですみます」
早めの対策で、カビ・ダニの繁殖を阻止しましょう。
<シャンプーボトル>ノズルについた液だれはカビの栄養源に!
すべての画像を見る(全7枚)シャンプーボトルに水気や液だれがあると、カビの栄養になり、大繁殖する危険大。「とくに見逃しがちなのがノズルの裏側の液だれ。手を経由し、細菌を体に移してしまう恐れが」と川上さんは言います。
【退治法】ノズルに付着したこびりつきは古歯ブラシでかき出し、水洗い。底や側面のヌメリや黒ズミもこすり洗いし、乾いた布で水気をふき取ってください。
【予防法】
使用後、液だれと水気をふき取ります。詰め替え時は、カビ菌がボトル内に入らないよう、必ずボトルとノズルを洗い、乾かしてから入れてるとよいでしょう。
<バスグッズ、オモチャ>使用後は乾燥を徹底し、カビさせない工夫を
綿棒で取った汚れをシャーレに移し、培養して測定。オモチャには数えきれないほど大量のカビや酵母菌があり、Hさんにとってはショックな結果でした。
洗面器やイスは床と接する底部分、オモチャは凹凸や継ぎ目にカビがつきがち。「オモチャは使用後に水をきるだけでいいと思っていました」というHさんに、「子どもの肌に触れるオモチャは、とりわけ健康被害に影響が。それだけでは危険です」と川上さんが警鐘を鳴らします。
【退治法】
消毒用エタノールで殺菌後、古歯ブラシ+水でこすり洗い。ゴム素材に付着したカビは塩素系漂白剤につけおきし、水でよく洗い流しましょう。
【予防法】
入浴後シャワーの水でさっと洗い流して。細かな部分は石けんカスなどが残らないよう、古歯ブラシでこすり、水気をふき取ります。
<浴室の排水口>汚れが集中するスポット。日々のケアは欠かさずに
お湯と一緒に石けんカスや髪の毛が流れ込んでいく排水口は、カビの生育にぴったりの環境。
「表面に黒ズミが見えてきたら、フタの裏側や内部にかなりのカビが発生していると考えてください」(川上さん)
【退治法】
フタを外し、溝部分をブラシと水でこすり洗い。こびりつき汚れは、塩素系漂白剤につけおきを。パイプ回りはスポンジ+水でこすります。
【予防法】
入浴後、髪の毛や石けんカスを取り除き、水で洗い流す習慣に。週に一度はフタを外し、内側についたヌメリや汚れをスポンジこすり洗いしましょう。
<浴室の壁や床、ドアのパッキン>カビ取り剤で湿布して徹底退治を
壁や床に石けんカスや皮脂が飛び散るとカビが繁殖。とりわけ壁の継ぎ目やタイルの目地、ドアのパッキンは要注意で、「汚れを放置するとカビが菌糸を生やすことに。徹底退治が必要です」(川上さん)
【退治法】
ティッシュペーパーでこよりをつくり、パッキンの溝にはめ、カビ取り剤をスプレー。壁の継ぎ目やタイルの目地も同様にし、ラップで30分ほど湿布してから、水で洗い流します。
【予防法】
入浴後、壁と床に飛び散った石けんや皮脂をシャワーで洗い流します。温水→冷水の順で流すのがコツ。パッキンや目地の水滴をふき取り、換気扇を回して十分に乾燥させましょう。
<バスマット>湿った時間が長いとカビが大繁殖。敷きっぱなし厳禁!
家族全員が使うバスマットは、1回の入浴でかなりの水分を吸収します。
「使用後敷きっぱなしにするとなかなか水気が抜けず、カビが大繁殖」(川上さん)
マットはもちろん、床までカビる危険性があります!
【退治法】
黒いポツポツした汚れは、カビ。衣類用の漂白剤につけおきし、その後洗濯機で洗います。カビ汚れの範囲が広く、落ちきらない場合は新しいものに交換しましょう。
【予防法】
入浴後はハンガーなどにかけて干し、乾燥させます。浴室の外に干す場所をつくるのがベター。2、3日に一度は洗濯機で洗い、天日干しすれば、すっきりします。
<バスタブのフタ>形状ごとにカビスポットを知り、重点的にケアを
湯気にさらされ、カビやすいフタ。じゃばら形は溝と裏側、平板形は縁のゴム素材、と形状によってカビがつきやすいスポットがあります。そこに狙いを定め、重点的にケアしましょう。
【退治法】
縁は、床にラップを敷いて中央にフタを置き、カビ取り剤をスプレー。周囲をラップで包むようにおおい、浸透させてから洗います。表面や溝はブラシ+水でこすり洗いをしてください。
【予防法】
入浴後、バスタブと一緒に洗います。溝部分や側面はとくに念入りに。洗ったあとは立てかけてよく乾燥させて。週に一度は天日干して殺菌すると、予防効果がアップします!
※本記事はESSE2015年7月号の記事を抜粋したものです